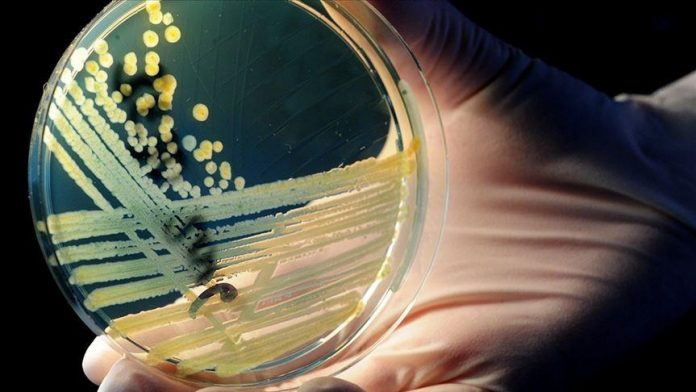
image

Studiuesit zbuluan se ky lloj i përshtatur ndaj të ftohtit i reziston 10 antibiotikëve nga tetë klasa të ndryshme.
“Lloji bakterial ‘Psychrobacter SC65A.3’, i izoluar nga akulli i Shpellës Scarisoara, pavarësisht origjinës së tij të lashtë, shfaq rezistencë ndaj shumë antibiotikëve modern dhe mbart mbi 100 gjene të lidhura me rezistencën”, tha Cristina Purcarea, autore e studimit dhe shkencëtare në Institutin e Biologjisë në Bukuresht të Akademisë Rumune.
Shpella përmban një bllok nëntokësor akulli rreth 13 mijë vjeçar me vëllim afër 100 mijë metra kub, që konsiderohet ndër më të mëdhenjtë dhe më të vjetrit në botë.
Sipas Purcarea-s, studimi i mikrobeve të tilla ndihmon shkencëtarët të kuptojnë se si rezistenca ndaj antibiotikëve ka evoluar natyrshëm shumë kohë përpara zhvillimit të ilaçeve moderne.
Studimi, i publikuar në revistën “Frontiers in Microbiology”, thekson rëndësinë e kërkimeve mbi mikroorganizmat e përshtatur ndaj të ftohtit, veçanërisht në kushtet kur habitatet e ngrira mbulojnë rreth 20 për qind të sipërfaqes së tokës dhe kur ndryshimet klimatike po përshpejtohen.
Rezistenca antimikrobike tashmë shkakton miliona vdekje çdo vit në nivel global, përfshirë mbi 35 mijë në Evropë, një shifër që pritet të rritet.